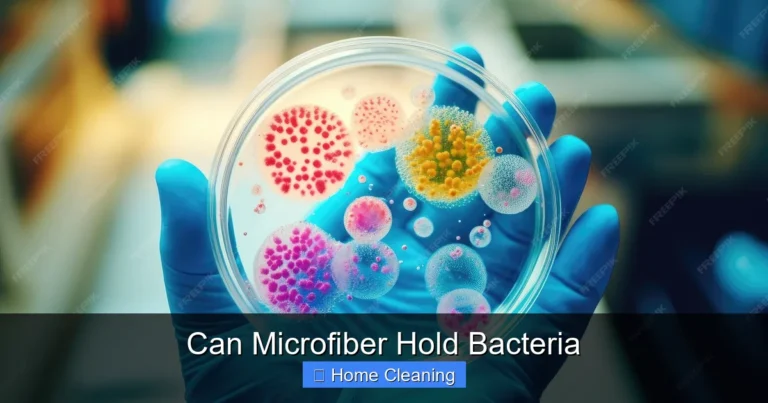
Can Microfiber Hold Bacteria

Are Microfiber Cloths Safe
Discover if microfiber cloths are safe for your home and health. Learn about their benefits, potential risks, and how to use them properly for effective clea…

Discover if microfiber cloths are safe for your home and health. Learn about their benefits, potential risks, and how to use them properly for effective clea…

Discover why microfiber cloths are a must-have in every home. Learn how these tiny powerhouses outperform traditional cloths in cleaning, protecting surfaces…

Discover the ultimate cleaning solution with our washable microfiber duster. Durable, reusable, and perfect for dusting furniture, electronics, and hard-to-r…

Discover why microfiber cloths develop unpleasant odors and how to eliminate them. Learn the science behind smelly microfiber and get practical, eco-friendly…

Discover what a microfiber duster is and how it revolutionizes home cleaning. Learn its uses, benefits, and tips for choosing the best microfiber duster for …

Feather Duster vs Microfiber: Which cleaning tool is better for your home? Discover the pros, cons, and ultimate winner in this detailed comparison guide.

Effortlessly clean dusty blinds with a microfiber duster for blinds—this lightweight, reusable tool removes dirt without harsh chemicals. Perfect for quick t…

Learn the best ways to dry microfiber cloths and extend their life with simple, effective methods. Keep your cleaning tools fresh and absorbent—naturally.
Discover whether microfiber can actually trap and hold bacteria. Learn the science behind microfiber cleaning, how it affects germs, and tips to keep your mi…

Learn the best ways to use a microfiber cloth for cleaning your home. Discover expert tips on how to use a microfiber cloth effectively for spotless results …